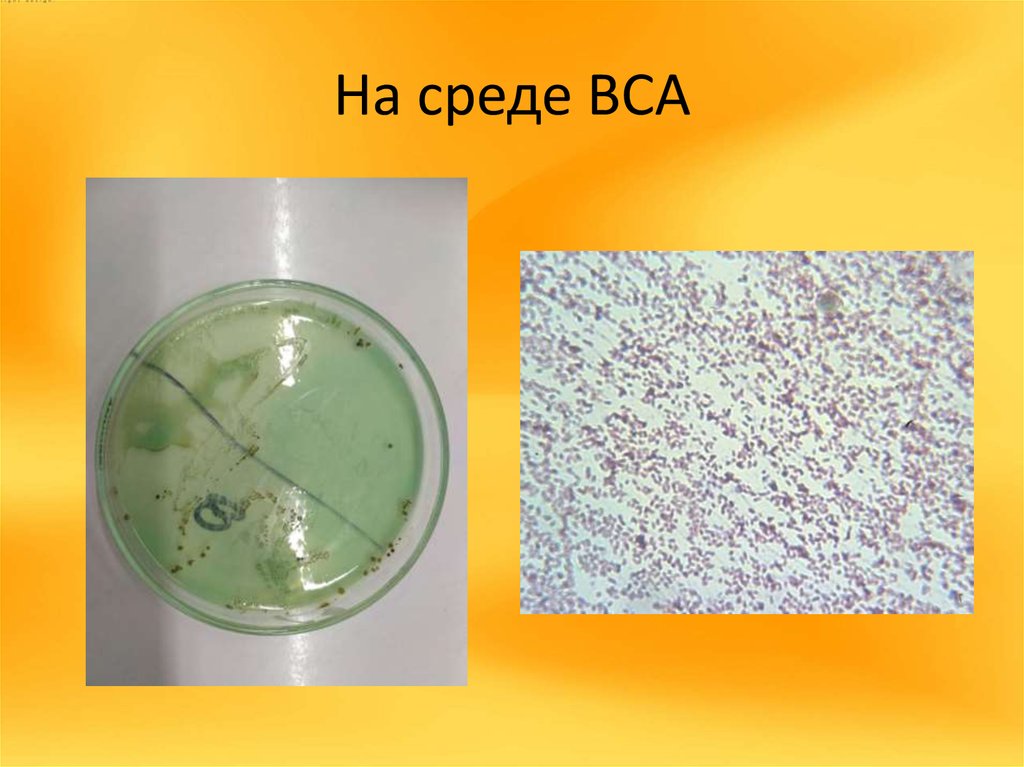
На среде ВСА

МИКРОБИОЛОГИЧЕСКОЕ
ИССЛЕДОВАНИЕ
МОЛОЧНЫХ ПРОДУКТОВ
ПРОДОВОЛЬСТВЕННЫХ
МАГАЗИНОВ Г. БАРНАУЛА
Выполнила:студентка 4 курса 545 группы Аксёнова А.М.
Научный руководитель — Федорова Г.А., к. вет. наук, ст.
преподаватель
4. «Активиа» №1
5. «Данон» №2
6. «Campina Нежный» №3
7. «Модест» №4
8. «Алтайская буренка» №5
9. «Молочная сказка» №6
10. «Белый замок» №7
11. «Чудо» №8
12. «Усть-Калманский маслосырзавод» №9
13. Закваска «VIVO» и молоко «Простоквашино»№10
14. Место проведения исследования
15. Проба № 1
16. Проба № 2
17. Проба № 3
18. Проба № 4
19. Проба № 5
20. Проба № 6
21. Проба № 7
22. Проба № 8
23. Проба № 9
24. Проба № 10
25. На среде ЭНДО
26. На среде ВСА
27. Проба №9 на ВСА
28. Спасибо за внимание

Биология
Биология








